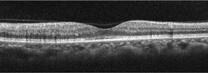

網膜とは
- 目の奥にある、光を感じる神経が集まった部分を「網膜(もうまく)」といいます。
- 網膜の中心にある「黄斑(おうはん)」は、視力を保つうえで重要なはたらきをしています。
- 網膜の血管と、その裏側にある脈絡膜(みゃくらくまく)の血管は、網膜に酸素や栄養を届けています。
- 網膜の検査では、瞳孔(どうこう)をひらく目薬をいれることがあります。その場合、4〜5時間は光がまぶしく、ピントが合いにくくなりますので、見え方が戻るまで車の運転を控えていただきます。


正常な網膜
目の表面から入ってきた光は角膜・水晶体・硝子体を通過して網膜に到達します。
網膜で得られた情報は、視神経を介して脳に伝達されます。
網膜の断層像では、黄斑が凹んでいることがわかります。